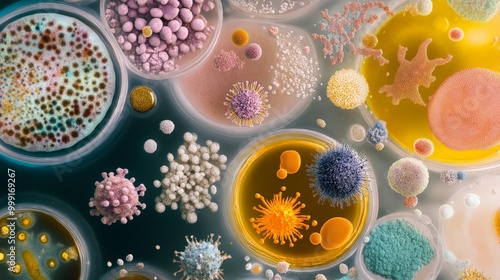

Download sample
File Details
Published: 2024-09-28 02:37:53.694903 Category: Science Type: Illustration Model release: NoShare
A microscopic view of bacteria, viruses, and fungi, showing the diversity of microorganisms in a petri dish.
Contributor: peerawat
ID : 999169267
